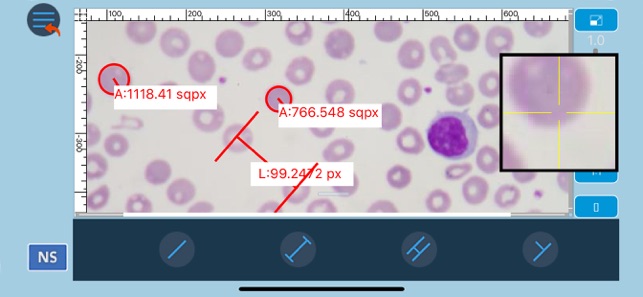

價格:免費
檔案大小:25.5 MB
版本需求:需要 iOS 10.0 或以上版本。與 iPhone 5s、iPhone 6、iPhone 6 Plus、iPhone 6s、iPhone 6s Plus、iPhone SE、iPhone 7、iPhone 7 Plus、iPhone 8、iPhone 8 Plus、iPhone X、iPhone XS、iPhone XS Max、iPhone XR、iPad Air、iPad Air Wi-Fi + Cellular、iPad mini 2、iPad mini 2 Wi-Fi + Cellular、iPad Air 2、iPad Air 2 Wi-Fi + Cellular、iPad mini 3、iPad mini 3 Wi-Fi + Cellular、iPad mini 4、iPad mini 4 Wi-Fi + Cellular、12.9 吋 iPad Pro、12.9 吋 iPad Pro Wi-Fi + Cellular、iPad Pro(9.7 吋)、iPad Pro(9.7 吋)Wi-Fi + 行動網路、iPad (第 5 代)、iPad(第五代)Wi-Fi + 行動網路、iPad Pro(12.9 吋)(第二代)、iPad Pro(12.9 吋)(第二代)Wi-Fi + 行動網路、iPad Pro(10.5 吋)、iPad Pro(10.5 吋)Wi-Fi + 行動網路、iPad (第六代)、iPad Wi-Fi + Cellular(第六代)、iPad Pro(11 吋)、iPad Pro(11 吋) Wi-Fi + 行動網路、iPad Pro(12.9 吋)、iPad Pro(12.9 吋)Wi-Fi + 行動網路、iPad mini(第 5 代)、 iPad mini(第 5 代)Wi-Fi + 行動網路、 iPad Air(第 3 代)、 iPad Air(第 3 代)Wi-Fi + 行動網路 及 iPod touch 相容。

The new NScope App from NOVEL Optics. This App let users do the following:
- Support for high resolution cameras
- Calibrate and save different measurements

- Add live and off-line measurements
- Add several annotations: line, circles, polygons, text, etc.
- Control Camera Parameters (HDR, Gain, Saturation, etc.)
- Support for interactive class
支援平台:iPhone, iPad
